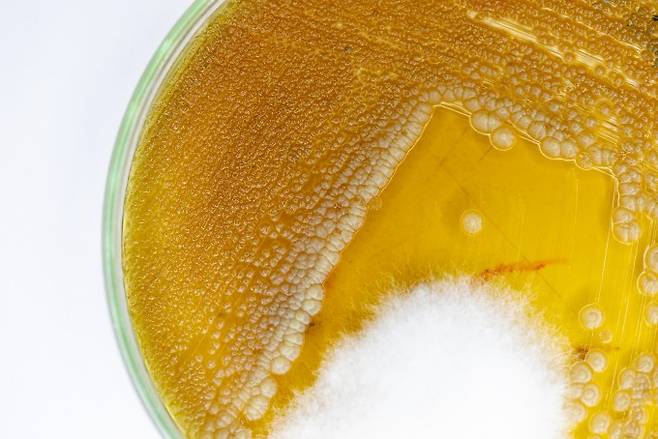
특정 종류의 암에 따라 곰팡이군이 달라진다는 연구 결과가 국제학술지 '셀' 9월 29일자에 두 편의 논문으로 발표됐다. 게티이미지뱅크 제공

곰팡이에서 암 단서 찾는다..특정 암에만 자라는 곰팡이군 존재
전체 맥락을 이해하기 위해서는 본문 보기를 권장합니다.
암의 종류에 따라 암 조직에 존재하는 곰팡이군의 종류가 달라진다는 내용을 담은 두 편의 논문이 국제학술지 '셀' 9월 29일자에 나란히 실렸다.
라비드 스트라우스만 이스라엘 와이즈만연구소 교수팀은 35종류의 암에 걸린 1만7000여개의 암 조직과 혈액 시료에서 곰팡이 개체군을 분석해 암 종류에 따른 곰팡이군을 분류했다.
효모 같은 경우 모든 유형의 암에 공통적으로 존재했지만 특정 종류의 곰팡이는 특정 암 조직에만 존재하며 암의 진행에 관여한다는 결과를 얻었다.
이 글자크기로 변경됩니다.
(예시) 가장 빠른 뉴스가 있고 다양한 정보, 쌍방향 소통이 숨쉬는 다음뉴스를 만나보세요. 다음뉴스는 국내외 주요이슈와 실시간 속보, 문화생활 및 다양한 분야의 뉴스를 입체적으로 전달하고 있습니다.
암의 종류에 따라 암 조직에 존재하는 곰팡이군의 종류가 달라진다는 내용을 담은 두 편의 논문이 국제학술지 '셀' 9월 29일자에 나란히 실렸다. 향후 암을 진단하거나 암의 경과를 예측할 때 활용할 수 있는 연구 결과다.
라비드 스트라우스만 이스라엘 와이즈만연구소 교수팀은 35종류의 암에 걸린 1만7000여개의 암 조직과 혈액 시료에서 곰팡이 개체군을 분석해 암 종류에 따른 곰팡이군을 분류했다. 효모 같은 경우 모든 유형의 암에 공통적으로 존재했지만 특정 종류의 곰팡이는 특정 암 조직에만 존재하며 암의 진행에 관여한다는 결과를 얻었다.
예를 들어 사람의 피부에서 흔하게 발견되는 곰팡이인 말라세시아 글로보사(Malassezia globosa)는 유방암 조직에 존재하며 환자의 생존율을 낮추는 데 관여했다. 아미 바하트 미국 스탠퍼드대 교수는 "곰팡이와 특정 암 사이에 연관성이 분명히 있지만 곰팡이가 직접적인 역할을 하는지는 아직 알 수 없다"고 말했다.
같은날 일리안 일리브 미국 웨일 코넬 의대 교수팀도 위장, 폐, 유방암을 조사한 결과 칸디다속, 블라스토미세스속, 말라세시아속 곰팡이가 발견됐다고 밝혔다. 연구팀은 위암 세포에서 발견되는 칸디다속 곰팡이가 염증을 촉진하는 유전자 활동을 촉진해 암의 전이율을 높이고 생존률은 낮춘다는 사실을 발견했다.
박테리아와 마찬가지로 곰팡이는 인체 내 미생물군집에 중요한 역할을 담당한다. 곰팡이를 비롯한 미생물군의 균형은 건강 상태나 질환 여부가 달라질 수도 있다. 다만 곰팡이는 미생물에 비해 개체수가 많지 않아 연구하기 까다로운 주제였다.
암과 곰팡이군의 상관관계를 연구하는 디팩 삭세나 미국 뉴욕주립대 치대 교수는 "암에서 곰팡이군을 추적하는 일은 마치 건초더미에서 바늘을 찾는 것 같다"며 "일반적으로 암세포 1만 개 중 하나 정도의 곰팡이가 발견된다"고 말했다.
곰팡이 연구는 오염될 가능성이 높다는 문제도 있다. 이번에 논문을 발표한 두 연구팀은 멸균 환경에서 실험을 진행하고 조직과 혈액 샘플에서 곰팡이를 직접 채취하는 방법으로 오염을 최소화했다고 밝혔다.
이번 연구 결과로 암과 곰팡이 사이 관련이 있다는 사실이 드러났지만 명확한 연관성을 제시하기 위해서는 더 많은 연구가 필요하다. 나딤 아마지 미국 MD 앤더슨 암센터 연구책임자는 "우리는 곰팡이, 박테리아와 공존하고 있다는 사실을 되새길 필요가 있다"며 곰팡이 연구의 중요성을 강조했다.
[이영애 기자 yalee@donga.com]
Copyright © 동아사이언스. 무단전재 및 재배포 금지.